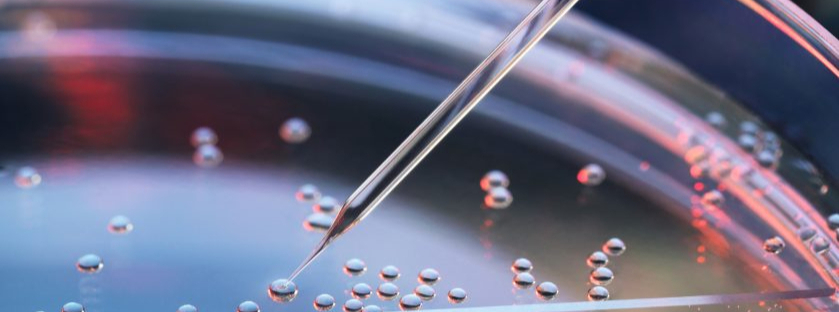
331355e2571e-GettyImages-961109594-copy-839x1200.jpg

Industries
A deep understanding of sector-specific environments, issues, and trends is critical to delivering relevant services to our clients, to anticipate and address evolving needs, as well as to capture opportunities. We put a strong focus on developing our sectoral expertise through our international sector communities. These bring together our experts from all corners of the globe who combine deep knowledge of specific sectors and understanding of local contexts and cultures with international perspective.
Consumer
Energy & infrastructure
Financial services
Life sciences
Helping life sciences companies have sustainable growth in an innovative manner to deliver better health outcomes for society
Manufacturing
Private equity
Public & social sector
Real estate
Technology, media & telecommunications

Innovative ideas for fast-growing, digitally connected technology, media and telecoms companies





